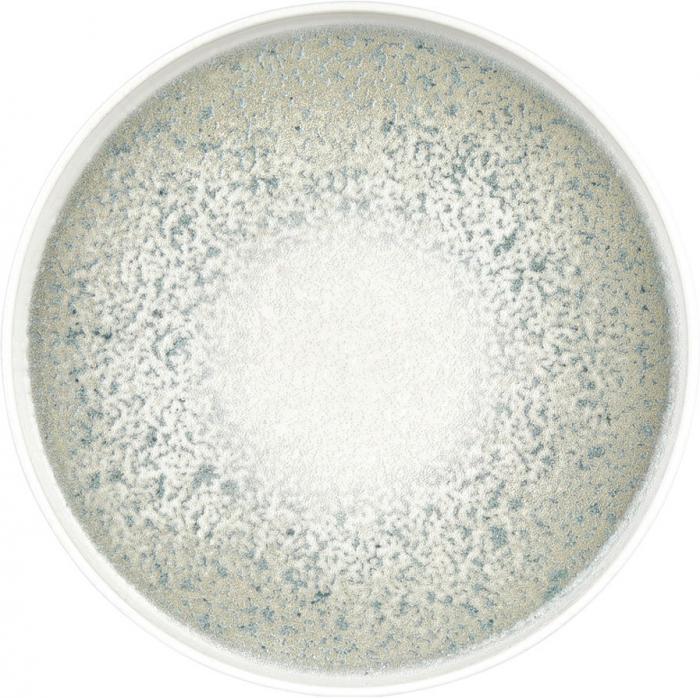

Тарелка обеденная By Bone NM-HL-27-RD. Опт - все предложения в Минске
Предложения Поставщиков
| Наименование от Поставщика | Цена, BYN | Продавец | Обновлено | Форма оплаты | Сроки |
|---|---|---|---|---|---|
| Тарелка столовая обеденная By Bone NM-HL-27-RD | 54.13 | Продавец 1 | 06.07.2026 23:14 | Нал/Безнал. | 1-3 дня |
Внимание! Сайт не является интернет-магазином. Информация, представленная на сайте, носит исключительно ознакомительный характер и ни при каких условиях не является публичной офертой. Чтобы купить товар, обращайтесь непосредствено к Продавцу.
Тарелка обеденная By Bone NM-HL-27-RD. Описание товара
|
Основные
|
|
|
Тип
Тип Посуда может быть представлена как наборами, так и отдельными предметами: тарелками различного размера, салатниками, супницами и другими предметами. |
тарелка обеденная |
|
Материал
Материал
Фарфор – тонкий и изысканный материал, из которого выполняются элитные сервизы. Фарфоровые чашки хорошо сохраняют тепло, при этом, не сильно нагреваясь, а сам сервиз обычно расписывается вручную. Кроме того, фарфор прост в уходе, а нанесенный декор будет долго сохранять свои цвета и контуры. Все это делает фарфоровый сервиз очень дорогим. Идеальный вариант для подарка. |
фарфор |
| Форма тарелки | круглая |
| Диаметр тарелки/ширина | 27 см |
|
Детский
Детский Наборы посуды для детей украшены героями мультфильмов или животными. |
|
Тарелка обеденная By Bone NM-HL-27-RD. Похожие товары
Зарегистрируйтесь или Авторизуйтесь.
Пополните баланс и активируйте доступ в Личном кабинете.